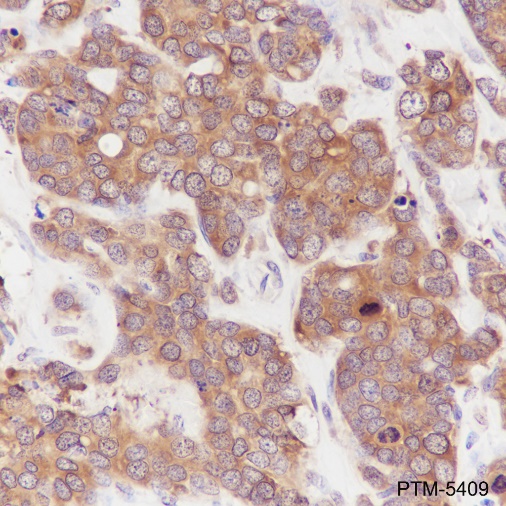

Background
The gene, HSP90AA1, encodes the human stress-inducible 90-kDa heat shock protein alpha (Hsp90A). Complemented by the constitutively expressed paralog Hsp90B which shares over 85% amino acid sequence identity, Hsp90A expression is initiated when a cell experiences proteotoxic stress. Once expressed Hsp90A dimers operate as molecular chaperones that bind and fold other proteins into their functional 3-dimensional structures. This molecular chaperoning ability of Hsp90A is driven by a cycle of structural rearrangements fueled by ATP hydrolysis. Current research on Hsp90A focuses in its role as a drug target due to its interaction with a large number of tumor promoting proteins and its role in cellular stress adaptation.
Cellular location
Membrane, Mitochondrion, Nucleus